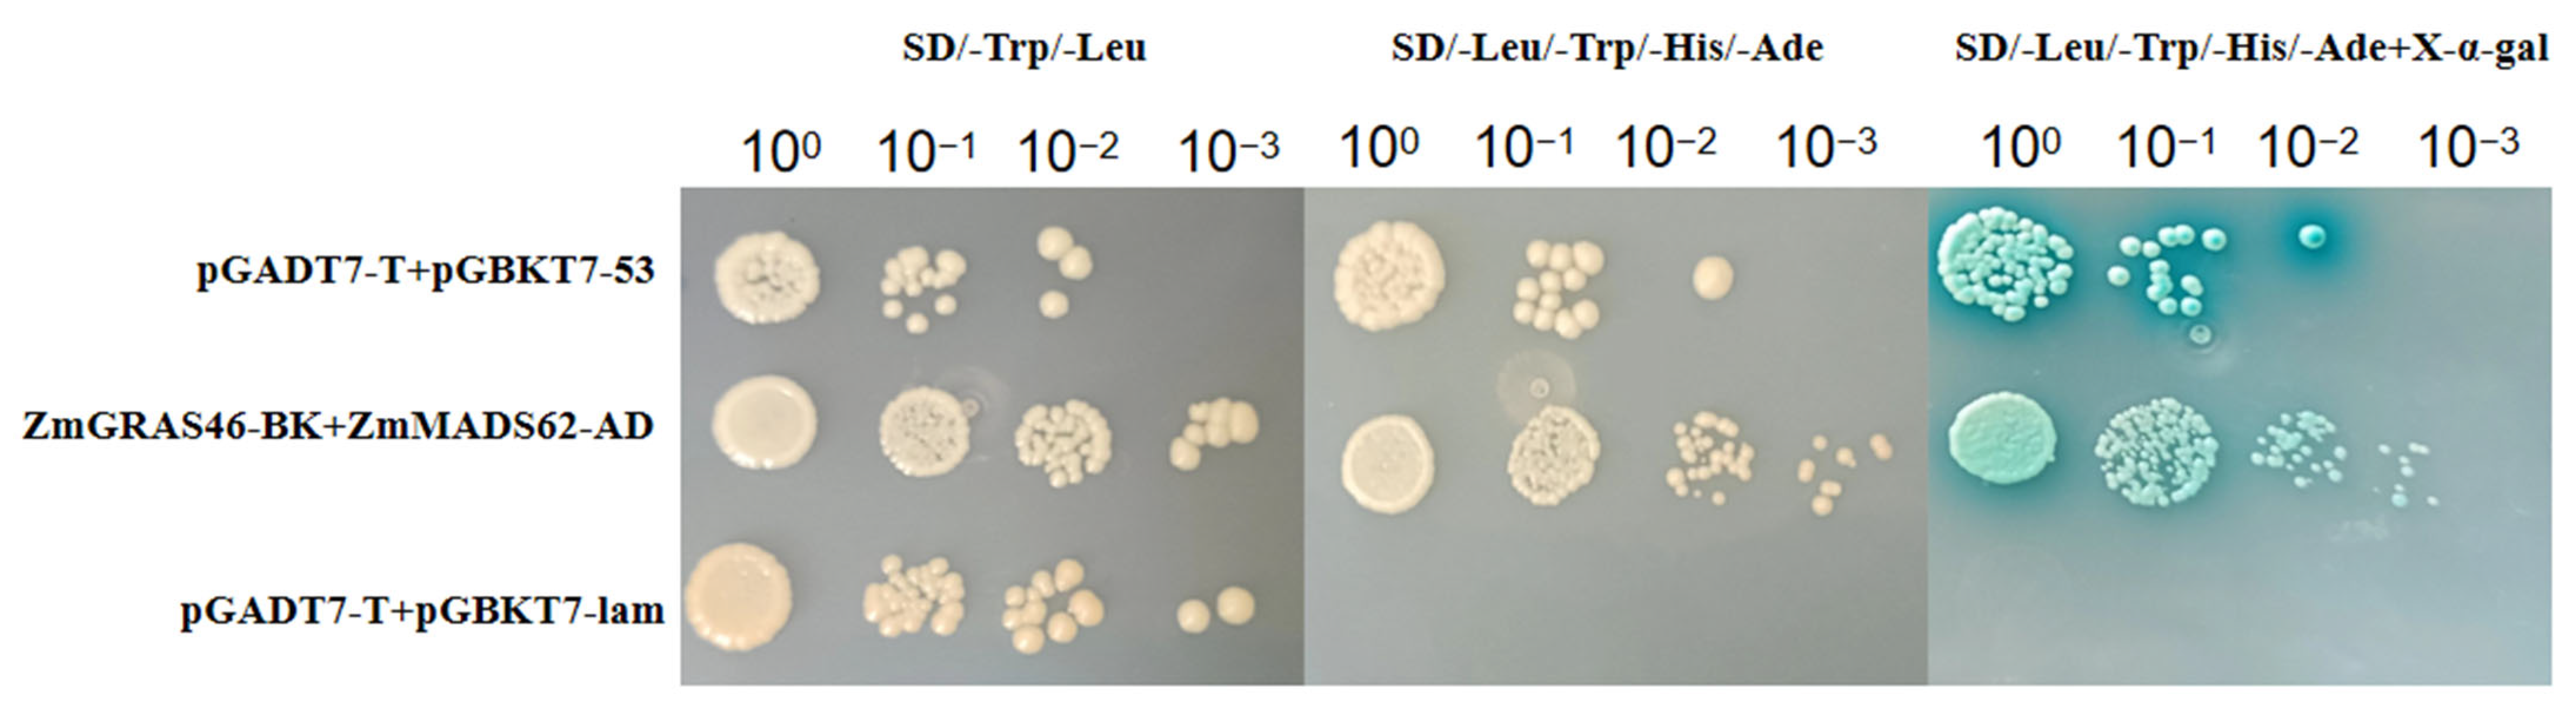
Agronomy 14 00155 g007

ZmGRAS46 Negatively Regulates Flowering Time in Arabidopsis thaliana
Abstract
1. Introduction
2. Materials and Methods
2.1. Plant Materials and Treatments
2.2. Generation of Constructs and Transgenic Plants
2.3. RNA Extraction, Reverse Transcription, and Gene Expression Quantification
2.4. Measurement of Physiological and Biochemical Indicators
2.5. Yeast Two-Hybrid (Y2H) Assay
2.6. Statistical Analysis
3. Results
3.1. Overexpression of ZmGRAS46 Inhibition Flowering
3.2. ZmGRAS46 Promotes Flower Bud Formation and Inhibits Floral Branch Elongation
3.3. Determination of Physiological and Biochemical Indices in T3 Generation of Arabidopsis thaliana Plants Transgenic for ZmGRAS46 after GA3 Treatment
3.4. ZmGRAS46 Is Dependent on the GA Pathway to Regulate Flowering
3.5. ZmGRAS46 Regulates Diverse Genes That Are Involved in Flowering Regulation
3.6. Interaction of ZmGRAS46 and ZmMADS62 Proteins
4. Discussion
5. Conclusions
Supplementary Materials
Author Contributions
Funding
Data Availability Statement
Conflicts of Interest
References
- Wasilewska, A.; Vlad, F.; Sirichandra, C.; Redko, Y.; Jammes, F.; Valon, C.; Frei, D.F.N.; Leung, J. An update on abscisic acid signaling in plants and more. Mol. Plant 2008, 1, 198–217. [Google Scholar] [CrossRef] [PubMed]
- Cheng, J.Z.; Zhou, Y.P.; Lv, T.X.; Xie, C.P.; Tian, C.E. Research progress on the autonomous flowering time pathway in Arabidopsis. Physiol. Mol. Biol. Plants 2017, 23, 477–485. [Google Scholar] [CrossRef]
- Kinmonth-Schultz, H.A.; Tong, X.; Lee, J.; Song, Y.H.; Ito, S.; Kim, S.H.; Imaizumi, T. Cool night-time temperatures induce the expression of CONSTANS and FLOWERING LOCUS T to regulate flowering in Arabidopsis. New Phytol. 2016, 211, 208–224. [Google Scholar] [CrossRef]
- Roussin-Leveillee, C.; Silva-Martins, G.; Moffett, P. ARGONAUTE5 Represses Age-Dependent Induction of Flowering through Physical and Functional Interaction with miR156 in Arabidopsis. Plant Cell Physiol. 2020, 61, 957–966. [Google Scholar] [CrossRef] [PubMed]
- Liu, Y.; Yang, N.; Yuan, H.; Chen, P.; Gu, R.; Zhang, Y. BraVRG, a novel protein of Brassica rapa, is induced by vernalization and promotes flowering in Arabidopsis thaliana. Plant Sci. 2023, 327, 111544. [Google Scholar] [CrossRef] [PubMed]
- Zhang, C.; Jian, M.; Li, W.; Yao, X.; Tan, C.; Qian, Q.; Hu, Y.; Liu, X.; Hou, X. Gibberellin signaling modulates flowering via the DELLA-BRAHMA-NF-YC module in Arabidopsis. Plant Cell 2023, 35, 3470–3484. [Google Scholar] [CrossRef] [PubMed]
- Bao, S.; Hua, C.; Shen, L.; Yu, H. New insights into gibberellin signaling in regulating flowering in Arabidopsis. J. Integr. Plant Biol. 2020, 62, 118–131. [Google Scholar] [CrossRef]
- Wang, S.; Duan, Z.; Yan, Q.; Wu, F.; Zhou, P.; Zhang, J. Genome-Wide Identification of the GRAS Family Genes in Melilotus albus and Expression Analysis under Various Tissues and Abiotic Stresses. Int. J. Mol. Sci. 2022, 23, 7403. [Google Scholar] [CrossRef]
- Guo, Y.; Wu, H.; Li, X.; Li, Q.; Zhao, X.; Duan, X.; An, Y.; Lv, W.; An, H. Identification and expression of GRAS family genes in maize (Zea mays L.). PLoS ONE 2017, 12, e0185418. [Google Scholar] [CrossRef]
- Sun, X.; Jones, W.T.; Rikkerink, E.H. GRAS proteins: The versatile roles of intrinsically disordered proteins in plant signalling. Biochem. J. 2012, 442, 1–12. [Google Scholar] [CrossRef]
- Gomez, M.D.; Cored, I.; Barro-Trastoy, D.; Sanchez-Matilla, J.; Tornero, P.; Perez-Amador, M.A. DELLA proteins positively regulate seed size in Arabidopsis. Development 2023, 150, dev201853. [Google Scholar] [CrossRef] [PubMed]
- Sarwar, R.; Jiang, T.; Ding, P.; Gao, Y.; Tan, X.; Zhu, K. Genome-wide analysis and functional characterization of the DELLA gene family associated with stress tolerance in B. napus. BMC Plant Biol. 2021, 21, 286. [Google Scholar] [CrossRef]
- Gomez, M.D.; Fuster-Almunia, C.; Ocana-Cuesta, J.; Alonso, J.M.; Perez-Amador, M.A. RGL2 controls flower development, ovule number and fertility in Arabidopsis. Plant Sci. 2019, 281, 82–92. [Google Scholar] [CrossRef] [PubMed]
- Takkis, K.; Tscheulin, T.; Petanidou, T. Differential Effects of Climate Warming on the Nectar Secretion of Early- and Late-Flowering Mediterranean Plants. Front. Plant Sci. 2018, 9, 874. [Google Scholar] [CrossRef]
- Liu, R.; Chen, J.; Zhang, Y.; Wang, P.; Kang, Y.; Li, B.; Dong, S. Physiological and Biochemical Characteristics of Prunus sibirica during Flowering. Sci. Hortic. 2023, 321, 112358. [Google Scholar] [CrossRef]
- Wolabu, T.W.; Tadege, M. Photoperiod response and floral transition in sorghum. Plant Signal Behav. 2016, 11, e1261232. [Google Scholar] [CrossRef] [PubMed]
- Jin, S.; Liu, C.; Jiao, P.; Fei, J.; Ma, Y.; Guan, S. Cloning and bioinformatics analysis of ZmSAMDC gene related to maize cold resistance. J. Jilin Agric. Univ. 2021, 6, 651–656. [Google Scholar]
- Bent, A. Arabidopsis thaliana floral dip transformation method. Methods Mol. Biol. 2006, 343, 87–103. [Google Scholar]
- Schmittgen, T.D.; Livak, K.J. Analyzing real-time PCR data by the comparative C(T) method. Nat. Protoc. 2008, 3, 1101–1108. [Google Scholar] [CrossRef]
- Xiang, Y.; Sun, X.; Bian, X.; Wei, T.; Han, T.; Yan, J.; Zhang, A. The transcription factor ZmNAC49 reduces stomatal density and improves drought tolerance in maize. J. Exp. Bot. 2021, 72, 1399–1410. [Google Scholar] [CrossRef]
- Bates, L.S.; Waldren, R.A.; Teare, I.D. Rapid determination of free proline for water-stress studies. Plant Soil. 1973, 39, 205–207. [Google Scholar] [CrossRef]
- Wang, C.; Chen, N.; Liu, J.; Jiao, P.; Liu, S.; Qu, J.; Guan, S.; Ma, Y. Overexpression of ZmSAG39 in maize accelerates leaf senescence in Arabidopsis thaliana. Plant Growth Regul. 2022, 98, 451–463. [Google Scholar] [CrossRef]
- Fitter, D.W.; Martin, D.J.; Copley, M.J.; Scotland, R.W.; Langdale, J.A. GLK gene pairs regulate chloroplast development in diverse plant species. Plant J. 2002, 31, 713–727. [Google Scholar] [CrossRef] [PubMed]
- Jiao, P.; Wei, X.; Jiang, Z.; Liu, S.; Guan, S.; Ma, Y. ZmLBD2 a maize (Zea mays L.) lateral organ boundaries domain (LBD) transcription factor enhances drought tolerance in transgenic Arabidopsis thaliana. Front. Plant Sci. 2022, 13, 1000149. [Google Scholar] [CrossRef]
- Zhou, S.; Hu, Z.; Li, F.; Yu, X.; Naeem, M.; Zhang, Y.; Chen, G. Manipulation of plant architecture and flowering time by down-regulation of the GRAS transcription factor SlGRAS26 in Solanum lycopersicum. Plant Sci. 2018, 271, 81–93. [Google Scholar] [CrossRef]
- Bethke, P.C.; Jones, R.L. Gibberellin signaling. Curr. Opin. Plant Biol. 1998, 1, 440–446. [Google Scholar] [CrossRef]
- Elliott, R.C.; Ross, J.J.; Smith, J.J.; Lester, D.R.; Reid, J.B. Feed-Forward Regulation of Gibberellin Deactivation in Pea. J. Plant Growth Regul. 2001, 20, 87–94. [Google Scholar]
- Hedden, P. The Current Status of Research on Gibberell in Biosynthesis. Plant Cell Physiol. 2020, 61, 1832–1849. [Google Scholar] [CrossRef]
- Abbas, M.; Imran, F.; Iqbal Khan, R.; Zafar-ul-Hye, M.; Rafique, T.; Jameel Khan, M.; Taban, S.; Danish, S.; Datta, R. Gibberellic Acid Induced Changes on Growth, Yield, Superoxide Dismutase, Catalase and Peroxidase in Fruits of Bitter Gourd (Momordica charantia L.). Horticulturae 2020, 6, 72. [Google Scholar] [CrossRef]
- Wang, J.; Wu, F.; Zhu, S.; Xu, Y.; Cheng, Z.; Wang, J.; Li, C.; Sheng, P.; Zhang, H.; Cai, M.; et al. Overexpression of OsMYB1R1-VP64 fusion protein increases grain yield in rice by delaying flowering time. FEBS Lett. 2016, 590, 3385–3396. [Google Scholar] [CrossRef]
- Li, C.; Lu, X.; Xu, J.; Liu, Y. Regulation of fruit ripening by MADS-box transcription factors. Sci. Hortic. 2023, 314, 111950. [Google Scholar] [CrossRef]
- Li, P.; Zhang, B.; Su, T.; Li, P.; Xin, X.; Wang, W.; Zhao, X.; Yu, Y.; Zhang, D.; Yu, S.; et al. BrLAS, a GRAS Transcription Factor From Brassica rapa, Is Involved in Drought Stress Tolerance in Transgenic Arabidopsis. Front. Plant Sci. 2018, 9, 1792. [Google Scholar] [CrossRef] [PubMed]
- Wang, H.; Li, J.; Liu, Z.; Wang, D. Dwarf phenotype induced by overexpression of a GAI1-like gene from Rhus chinensis. Plant Cell Tissue Organ Cult. (Pctoc) 2022, 151, 617–629. [Google Scholar] [CrossRef]
- Xie, Z.; Yang, D.; Zhou, Z.; Li, K.; Yi, P.; Liu, A.; Zhou, Z.; Tu, X. A genome-wide analysis of the GRAS gene family in upland cotton and a functional study of the role of the GhGRAS55 gene in regulating early maturity in cotton. Biotechnol. J. 2023, 18, 2300201. [Google Scholar] [CrossRef] [PubMed]
- Wang, Y.; Song, S.; Hao, Y.; Chen, C.; Ou, X.; He, B.; Zhang, J.; Jiang, Z.; Li, C.; Zhang, S.; et al. Role of BraRGL1 in regulation of Brassica rapa bolting and flowering. Hortic. Res. 2023, 10, uhad119. [Google Scholar] [CrossRef] [PubMed]
- Habib, S.; Waseem, M.; Li, N.; Yang, L.; Li, Z. Overexpression of SlGRAS7 Affects Multiple Behaviors Leading to Confer Abiotic Stresses Tolerance and Impacts Gibberellin and Auxin Signaling in Tomato. Int. J. Genom. 2019, 2019, 4051981. [Google Scholar] [CrossRef] [PubMed]
- Huang, W.; Peng, S.; Xian, Z.; Lin, D.; Hu, G.; Yang, L.; Ren, M.; Li, Z. Overexpression of a tomato miR171 target gene SlGRAS24 impacts multiple agronomical traits via regulating gibberellin and auxin homeostasis. Plant Biotechnol. J. 2017, 15, 472–488. [Google Scholar] [CrossRef]
- Suarez-Lopez, P.; Wheatley, K.; Robson, F.; Onouchi, H.; Valverde, F.; Coupland, G. CONSTANS mediates between the circadian clock and the control of flowering in Arabidopsis. Nature 2001, 410, 1116–1120. [Google Scholar] [CrossRef]
- Jing, Y.; Lin, R. Transcriptional regulatory network of the light signaling pathways. New Phytol. 2020, 227, 683–697. [Google Scholar] [CrossRef]
- Li, M.; An, F.; Li, W.; Ma, M.; Feng, Y.; Zhang, X.; Guo, H. DELLA proteins interact with FLC to repress flowering transition. J. Integr. Plant Biol. 2016, 58, 642–655. [Google Scholar] [CrossRef]
- Gautam, V.; Swaminathan, M.; Akilan, M.; Gurusamy, A.; Suresh, M.; Kaithamalai, B.; Joel, A.J. Early flowering, good grain quality mutants through gamma rays and EMS for enhancing per day productivity in rice (Oryza sativa L.). Int. J. Radiat. Biol. 2021, 97, 1716–1730. [Google Scholar] [CrossRef] [PubMed]
- Zeleke, K.T.; Nendel, C. Analysis of options for increasing wheat (Triticum aestivum L.) yield in south-eastern Australia: The role of irrigation, cultivar choice and time of sowing. Agric. Water Manag. 2016, 166, 139–148. [Google Scholar] [CrossRef]
- Shavrukov, Y.; Kurishbayev, A.; Jatayev, S.; Shvidchenko, V.; Zotova, L.; Koekemoer, F.; de Groot, S.; Soole, K.; Langridge, P. Early Flowering as a Drought Escape Mechanism in Plants: How Can It Aid Wheat Production? Front. Plant Sci. 2017, 8, 1950. [Google Scholar] [CrossRef] [PubMed]
- Hussin, S.H.; Wang, H.; Tang, S.; Zhi, H.; Tang, C.; Zhang, W.; Jia, G.; Diao, X. SiMADS34, an E-class MADS-box transcription factor, regulates inflorescence architecture and grain yield in Setaria italica. Plant Mol. Biol. 2021, 105, 419–434. [Google Scholar] [CrossRef]
- Song, G.Q.; Han, X. K-Domain Technology: Constitutive Expression of a Blueberry Keratin-Like Domain Mimics Expression of Multiple MADS-Box Genes in Enhancing Maize Grain Yield. Front. Plant Sci. 2021, 12, 664983. [Google Scholar] [CrossRef]
- Wu, J.; Lawit, S.J.; Weers, B.; Sun, J.; Mongar, N.; Van Hemert, J.; Melo, R.; Meng, X.; Rupe, M.; Clapp, J.; et al. Overexpression of zmm28 increases maize grain yield in the field. Proc. Natl. Acad. Sci. USA 2019, 116, 23850–23858. [Google Scholar] [CrossRef]

Disclaimer/Publisher’s Note: The statements, opinions and data contained in all publications are solely those of the individual author(s) and contributor(s) and not of MDPI and/or the editor(s). MDPI and/or the editor(s) disclaim responsibility for any injury to people or property resulting from any ideas, methods, instructions or products referred to in the content. |
© 2024 by the authors. Licensee MDPI, Basel, Switzerland. This article is an open access article distributed under the terms and conditions of the Creative Commons Attribution (CC BY) license (https://creativecommons.org/licenses/by/4.0/).
Share and Cite
Zhang, H.; Jiang, Z.; Jiao, P.; Zhao, Y.; Gao, B.; Liu, S.; Guan, S.; Ma, Y. ZmGRAS46 Negatively Regulates Flowering Time in Arabidopsis thaliana. Agronomy 2024, 14, 155. https://doi.org/10.3390/agronomy14010155
Zhang H, Jiang Z, Jiao P, Zhao Y, Gao B, Liu S, Guan S, Ma Y. ZmGRAS46 Negatively Regulates Flowering Time in Arabidopsis thaliana. Agronomy. 2024; 14(1):155. https://doi.org/10.3390/agronomy14010155
Chicago/Turabian StyleZhang, Honglin, Zhenzhong Jiang, Peng Jiao, Yang Zhao, Bai Gao, Siyan Liu, Shuyan Guan, and Yiyong Ma. 2024. "ZmGRAS46 Negatively Regulates Flowering Time in Arabidopsis thaliana" Agronomy 14, no. 1: 155. https://doi.org/10.3390/agronomy14010155
APA StyleZhang, H., Jiang, Z., Jiao, P., Zhao, Y., Gao, B., Liu, S., Guan, S., & Ma, Y. (2024). ZmGRAS46 Negatively Regulates Flowering Time in Arabidopsis thaliana. Agronomy, 14(1), 155. https://doi.org/10.3390/agronomy14010155

